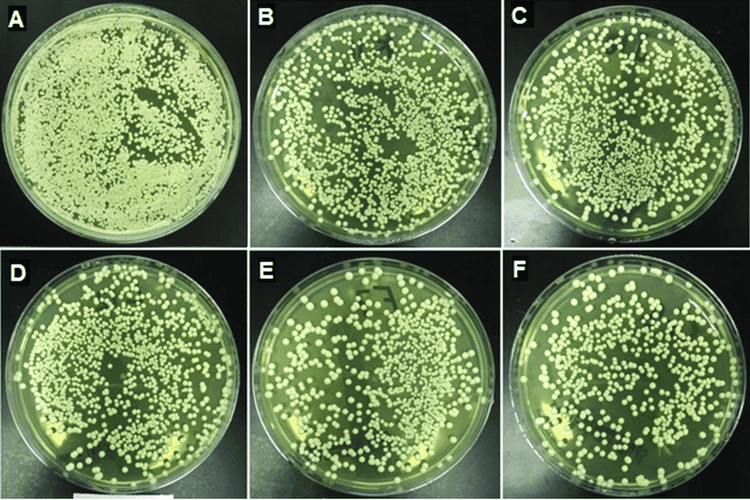

Sốt kéo dài do nấm là do tác nhân nấm gây nên. Sốt kéo dài do nấm thường diễn ra nhiều tuần, trong một số trường hợp kéo dài đến hàng tháng. Sốt kéo dài do nấm có thể là do nhiễm khuẩn huyết do nấm candida albicans hoặc do Torulose.
1. Sốt kéo dài do nấm là gì?
Sốt là tình trạng khi thân nhiệt trên 37,5 độ C nếu cặp ở miệng và trên 38 độ C ở hậu môn. Sốt không phải là bệnh mà chính là triệu chứng của nhiều nguyên nhân. Một trong những nguyên nhân chủ yếu là do virus và vi khuẩn. Sốt kéo dài là một hội chứng thường gặp trong khoa truyền nhiễm. Đặc điểm chính là sốt, một số dấu hiệu khác thường không và nếu có thì rất mờ nhạt.
Sốt kéo dài do nấm là do tác nhân nấm gây nên. Sốt kéo dài do nấm thường diễn ra nhiều tuần, trong một số trường hợp kéo dài đến hàng tháng. Sốt kéo dài do nấm có thể là do nhiễm khuẩn huyết do nấm candida albicans hoặc do Torulose.
2. Nhận diện sốt kéo dài do nấm
Để nhận diện sốt kéo dài do nấm, người bệnh có thể dựa vào các dấu hiệu sau đây:
- Đối với nhiễm khuẩn huyết do nấm Candida albicans: Triệu chứng sốt thất thường, những cơn sốt rất ngắn 1 - 2 lần trong ngày và nó thường xảy ra đối với những bệnh nặng như bệnh máu hay nhiễm HIV và đã dùng kháng sinh tĩnh mạch kéo dài. Chẩn đoán nhiễm khuẩn huyết do nấm Candida albicans dựa vào tưa ở miệng, nhiễm khuẩn xung quanh ống thông, nấm ở da và có di căn nấm ở thận, nội tâm mạc, phổi, màng não và mắt.... Trong trường hợp cấy máu thì sẽ xuất hiện nhiễm trùng nấm, chẩn đoán huyết thanh dương tính.
- Torulose (Cryptococcus) thường xảy ra ở người suy yếu, có bệnh nền như Hodgkin, ung thư, bệnh máu hoặc bệnh sarcoidose. Ngoài ra, người bệnh có dấu hiệu não - màng não kéo dài, tế bào dịch não tuỷ tăng do lympho; có sự xuất hiện của nấm Cryptococcus neoformans; sờ có hạch sưng to, gan lách to. Trong trường hợp này người bệnh thường chết sau vài tháng nếu không được chẩn đoán và điều trị nhiễm trùng nấm kịp thời.
3. Chăm sóc người bệnh sốt kéo dài do nấm
Những người bị sốt kéo dài nói chung cần được chăm sóc để làm giảm các triệu chứng do sốt gây ra. Bởi sốt có thể gây mất nước, ảnh hưởng tới sức khỏe người bệnh. Chăm sóc người bệnh sốt kéo dài do nấm bao gồm:
Hạ sốt thích hợp:
- Sốt là một phản ứng, không phải là bệnh: Sốt giúp cơ thể người bệnh tăng cường mọi hoạt động chống nhiễm khuẩn, hỗ trợ hệ miễn dịch đặc hiệu và không đặc hiệu. Do đó, sốt là một yếu tố bảo vệ, không nhất thiết phải hạ sốt bằng thuốc, bởi các thuốc hạ nhiệt có thể gây tổn thương máu, giảm sức miễn dịch và giảm sức đề kháng, làm lu mờ bệnh cảnh điển hình, từ đó dẫn đến việc khó khăn cho việc chẩn đoán.
- Tuy nhiên, trong một số trường hợp, nhất là với trẻ em, do thân nhiệt chưa được điều chỉnh vững bền nên nếu để sốt quá cao có thể gây co giật. Vì vậy, trường hợp cần thiết có thể dùng các biện pháp vật lý, mặc quần áo rộng rãi và thoáng mát, ngừa các cơn co giật do sốt bằng các thuốc an thần và dùng các thuốc hạ nhiệt.
Bổ sung đủ nước cho người bị sốt kéo dài:
- Người bệnh sốt kéo dài thường sẽ thiếu nước dẫn đến nguy cơ mất nước. Thông thường, một người cần đáp ứng đủ một khối lượng nước gồm: 250ml nước nội sinh trong chuyển hoá, lượng nước uống thường ngày, lượng nước bằng 70% lượng thức ăn rắn, lượng nước thải ra qua nước tiểu và qua phân, lượng nước thải qua đường hô hấp (700ml), lượng nước bốc hơi qua da. Như vậy, cần bổ sung khoảng 2 - 3 lít ngày cho người bị sốt kéo dài, tới khi lượng nước tiểu đạt 1 lít/ngày.
- Đối với trẻ em, thiếu nước cũng có thể gây sốt cao. Do đó, cần bổ sung cho lượng nước tuần hoàn đủ lại thì sẽ đảm bảo cho việc thải nhiệt được tốt.
Ăn đủ, chú ý tới đạm:
- Người sốt kéo dài thường sẽ bị rối loạn tiêu hóa. Các triệu chứng rối loạn tiêu hóa đó bao gồm chán ăn, buồn nôn và nôn, đi lỏng hoặc một số trường hợp táo bón.... Ăn uống không đủ chất dinh dưỡng sẽ dẫn tới sụt cân nhanh do đạm ở tổ chức bị tiêu hao. Do đó, sốt càng cao thì nhu cầu đạm lại càng tăng. Nhu cầu đạm cho người sốt kéo dài là ăn đủ khoảng 2.100 - 3.000 calo/ ngày.
- Về vitamin nên dùng vitamin như thường lệ. Bởi ở người sốt, vitamin không bị phân huỷ nhiều hơn so với người khỏe mạnh, vì vậy cần cho người sốt kéo dài ăn nhiều bữa, hợp khẩu vị.
- Chế độ dinh dưỡng cho người bệnh sốt kéo dài do nhiễm nấm có vai trò quan trọng trong việc điều trị bệnh.

Bất động:
- Ở người bệnh bị sốt kéo dài, không nên bất động tuyệt đối nếu không có chống chỉ định để tránh gây nghẽn mạch do đông máu. Vì vậy, có thể cho người bệnh ngồi ghế vài giờ trong ngày.
Về điều trị:
- Trong một số trường hợp cần thiết, có thể dùng thuốc điều trị để thử. Tuy nhiên, việc thử thuốc cần phải có đủ tài liệu về bệnh sử, bệnh trạng, triệu chứng, xét nghiệm của người bệnh dù chưa có chẩn đoán chính xác.
- Để việc chẩn đoán cũng như điều trị sau này dễ dàng hơn cần tránh việc dùng bừa bãi, vội vàng. Đồng thời cần tầm soát nguyên nhân nhiễm trùng nấm và điều trị sớm đối với những người bệnh sốt kéo dài, đã cho dùng kháng sinh kéo dài và nằm viện lâu ngày.
Tóm lại, người bệnh cần đến bệnh viện uy tín để tiến hành thăm khám và điều trị ngay khi có dấu hiệu của sốt kéo dài do nấm. Hiện nay, Bệnh viện Đa khoa Quốc tế Vinmec là một trong những bệnh viện uy tín được đông đảo người bệnh tin tưởng thăm khám và điều trị bệnh. Không chỉ có hệ thống cơ vật chất, trang thiết bị hiện đại: 6 phòng siêu âm, 4 phòng chụp X- quang DR (1 máy chụp toàn trục, 1 máy tăng sáng, 1 máy tổng hợp và 1 máy chụp nhũ ảnh), 2 máy chụp Xquang di động DR, 2 phòng chụp cắt lớp vi tính đa dãy đầu thu (1 máy 128 dãy và 1 máy 16 dãy), 2 phòng chụp Cộng hưởng từ (1 máy 3 Tesla và 1 máy 1.5 Tesla), 1 phòng chụp mạch máu can thiệp 2 bình diện và 1 phòng đo mật độ khoáng xương....Vinmec còn là nơi quy tụ đội ngũ các y, bác sĩ giàu kinh nghiệm sẽ hỗ trợ phần nhiều trong việc chẩn đoán và phát hiện sớm những dấu hiệu bất thường của cơ thể người bệnh.
Để đặt lịch khám tại viện, Quý khách vui lòng bấm số HOTLINE hoặc đặt lịch trực tiếp TẠI ĐÂY. Tải và đặt lịch khám tự động trên ứng dụng MyVinmec để quản lý, theo dõi lịch và đặt hẹn mọi lúc mọi nơi ngay trên ứng dụng.





